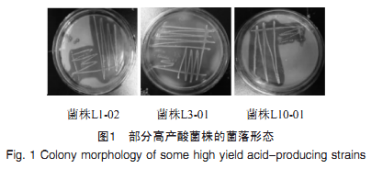

于云南建水、陜西榆林、山東鄒平、河北淶源、云南石屏以及北京延慶等地的7個(gè)酸漿豆腐廠采集樣品,涵蓋我國(guó)主要酸漿豆腐產(chǎn)地。豆腐酸漿老湯樣品采集情況見(jiàn)表1。

由表1可知,我國(guó)不同地區(qū)的豆腐酸漿老湯的pH值存在一定差異,其中取自陜西榆林的2號(hào)樣品pH值最高,為3.63;取自山東鄒平的3號(hào)樣品pH值最低,為2.45。其余樣品pH值均在2.71~3.02之間,呈酸性。結(jié)果表明,采集的豆腐酸漿老湯樣品pH值范圍與趙貴麗等采用黃漿水發(fā)酵制成的酸漿老湯pH值基本一致。
通過(guò)含2%CaCO3MRS培養(yǎng)基從7種豆腐酸漿老湯樣品中共分離篩選出31株溶鈣圈較明顯的產(chǎn)酸菌,通過(guò)菌落形態(tài)、顯微鏡鏡檢最終篩選出16株菌落形態(tài)差異較大的菌株。經(jīng)過(guò)發(fā)酵產(chǎn)酸能力測(cè)定后,每種樣品中選取發(fā)酵液pH最低的菌株視為該樣品中的高產(chǎn)酸菌株,共7株,分別編號(hào)為L(zhǎng)1-02、L2-03、L3-01、L6-07、L7-01、L8-03、L10-01。
7株高產(chǎn)酸菌株中,部分菌株在CaCO3-MRS培養(yǎng)基上的菌落形態(tài)及細(xì)胞形態(tài)分別見(jiàn)圖1、圖2。

由圖1可知,菌落均為乳白色,邊緣較為整齊,單個(gè)菌落半徑較小,呈圓形,半透明狀態(tài)。由圖2可知,經(jīng)過(guò)革蘭氏染色后,均為紫色革蘭氏陽(yáng)性菌,菌體呈桿狀與短棒狀,符合乳酸菌菌落形態(tài)與菌體特征。
將7株高產(chǎn)酸菌株的DNA序列提交至NCBI的GenBank數(shù)據(jù)庫(kù)中進(jìn)行BLAST比對(duì),井使用MEGA-X10.1軟件構(gòu)建系統(tǒng)發(fā)育樹(shù),結(jié)果見(jiàn)圖3。

由圖3可知,菌株L2-03、L3-01、L6-07、L7-01與玉米乳桿菌聚于一支,菌株L1-02、L8-03、L10-01與副干酪乳桿菌聚于一支,親緣關(guān)系最近。因此,綜合形態(tài)學(xué)鑒定結(jié)果,將菌株L2-03、L3-01、L6-07、L7-01鑒定為玉米乳桿菌,菌株L1-02、L8-03、L10-01鑒定為副干酪乳桿菌。
7株高產(chǎn)酸乳酸菌發(fā)酵過(guò)程中總酸產(chǎn)量及pH值的變化結(jié)果見(jiàn)圖4。

由圖4a可知,菌株L2-03、L3-01、L6-07、L7-01的產(chǎn)酸量在0~20h內(nèi)增速基本維持不變,增幅明顯;菌株L1-02、L8-03、L10-01產(chǎn)酸量在14h后增速逐漸放緩,曲線逐漸平穩(wěn)。最終在生長(zhǎng)36h后產(chǎn)酸曲線基本到達(dá)終點(diǎn)。其中,菌株L6-07產(chǎn)酸速度最快,產(chǎn)酸量最高,達(dá)25.69g/L,產(chǎn)酸性能明顯高于其他菌株;菌株L3-01產(chǎn)酸量次之,達(dá)25.01g/L;菌株L1-02、L8-03產(chǎn)酸量較低,分別為17.51g/L、17.15g/L,產(chǎn)酸速率也較慢。其他研究者也從豆腐酸漿老湯中篩選出高產(chǎn)酸菌,如葉青等從豆腐酸漿中篩選出高產(chǎn)酸的干酪乳桿菌,發(fā)酵48h時(shí),產(chǎn)酸量為27g/L;王國(guó)良分離出的高產(chǎn)酸菌發(fā)酵48h后產(chǎn)酸量為24.9g/L。本研究從陜西榆林豆腐酸漿老湯中篩選出的菌株L6-07發(fā)酵48h后產(chǎn)酸量為25.69g/L,相較于其他研究者所篩選出的產(chǎn)酸菌產(chǎn)酸量處于較高水平。
由圖4b可知,在0~20h內(nèi),7株菌的pH值下降明顯;菌株L6-07的pH值下降最快,降至3.26,說(shuō)明產(chǎn)酸能力最強(qiáng);菌株L1-02的pH值下降最慢,降至4.01,說(shuō)明產(chǎn)酸能力最弱;與圖4a結(jié)論相符。發(fā)酵液pH值在24h后基本維持不變,說(shuō)明乳酸菌在24h后基本不再生長(zhǎng)。
聲明:本文所用圖片、文字來(lái)源《中國(guó)食品添加劑》,版權(quán)歸原作者所有。如涉及作品內(nèi)容、版權(quán)等問(wèn)題,請(qǐng)與本網(wǎng)聯(lián)系
相關(guān)鏈接:豆腐,干酪乳桿菌,革蘭氏陽(yáng)性菌